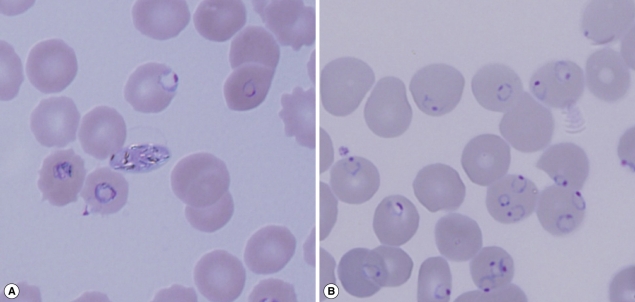
0

Abstract
A 57-year old man who was admitted to an emergency room of a tertiary hospital with hemoptysis developed malarial fever 19 days later and then died from severe falciparum malaria 2 days later. He had not traveled outside of Korea for over 30 years. Through intensive interviews and epidemiological surveys, we found that a foreign patient with a recent history of travel to Africa was transferred to the same hospital with severe falciparum malaria. We confirmed through molecular genotyping of the MSP-1 gene that Plasmodium falciparum genotypes of the 2 patients were identical. It is suggested that a breach of standard infection control precautions resulted in this P. falciparum transmission between 2 patients in a hospital environment. This is the first report of a nosocomial transmission of falciparum malaria in Korea.
-
Key words: Plasmodium falciparum, malaria, nosocomial transmission
INTRODUCTION
Only vivax malaria is prevalent in border areas of the Republic of Korea (= Korea) and North Korea. It is acquired mainly through the bite of an infected
Anopheles mosquito during the summer season and is a reportable communicable disease in Korea. Between 2003 and 2007, a total of 7,682 cases of locally transmitted vivax malaria and 212 cases of imported falciparum malaria were reported in Korea [
1]. Although nosocomial transmission of malaria is rare in non-endemic areas, several cases have been reported [
2-
5]. In 2006, in Korea, 1 vivax case transmitted via blood transfusion was reported [
6]. In January 2007, we received a report of falciparum malaria in a patient who had not traveled outside of Korea. Here we report the first domestic case of falciparum malaria acquired through nosocomial transmission in the emergency room of a tertiary hospital in Korea. We confirmed this by molecular genotyping.
CASE REPORTS
Case 1
On 29 December 2006, a 57-year old man, suffering from pulmonary tuberculosis was admitted with hemoptysis to the emergency room of a tertiary hospital in Korea. Fourteen days after admission, the patient developed the first fever episode. This developed into a high fever with concomitant anemia, thrombocytopenia, and increased bilirubin levels. Because these symptoms were similar to those of malaria, a peripheral blood smear was requested, and the patient was diagnosed as falciparum malaria with 18% parasitemia. Despite treatment with 750 mg mefloquine on 23 January 2007, the patient died from severe malaria on 24 January 2007.
Case 2
On 24 December, 2006, 5 days before the admission of Case 1, a 59-year old Greek man entered through Incheon International Airport of Korea. He had traveled in Nigeria and Congo for 3 months before entry into Korea. He developed fever 2 days before entry into Korea and was admitted to a primary hospital complaining fever, cough, and muscle pain on 25 December 2006. Because of ingravescence of symptoms he was transferred to the emergency room of this hospital, which is 2 km away from the first hospital, on 30 December 2009. He was diagnosed as severe complicated falciparum malaria with 40% parasitemia. The patient stayed in the emergency room and received immediate attention with blood examination, but died 9 hr later on the same day.
MATERIALS AND METHODS
Procedures
After the diagnosis of falciparum malaria was confirmed in Case 1, an intensive investigation on how he acquired the infection was initiated. The patient lived in Yangsan city in a southern part of Korea. Neither he, nor his family, traveled to any area in or out of the country where malaria is endemic. Case 1 was in Vietnam from February 1970 to February 1971, but had never been out of the country since then. The patient suffered from the after-effects of dioxine. Because of this, he stayed at home, or was in hospital, since 2006. He did not reside near a harbor or an airport. Although
Anopheles sinensis,
Anopheles kleini,
Anopheles lesteri, and
Anopheles pullus are vectors for vivax malaria in Korea [
7-
9], the vector mosquito responsible for falciparum malaria has never been found in Korea. In addition, it has never been associated with the airport, so the possibility of luggage malaria was excluded. Furthermore, this malaria case occurred during the winter season when temperatures ranged from 0 to 10℃, which is not suitable for mosquito survival.
Case 1 had undergone transfusions 3 times (22 September 2006; 19 January 2007; 21 January 2007), but the serologic and PCR examinations of the blood had no indication of malaria. There was no history of intravenous drug use which was confirmed through the family interviews. After reviewing all medical records from the hospital, we found that these 2 falciparum malaria cases were hospitalized in the emergency room at the same time. They were in the same emergency room for 9 hr and were given several emergency diagnostic and therapeutic treatments. The 2 patients were approximately 7 m apart. Case 1 received intravenous fluid via a peripheral vein and his gastrostomy incision site was disinfected and the dressing was changed. The interventions of Case 2 consisted of blood examination, central vein catheter insertion, intubation, mechanical ventilation, and cardiac massage. It is possible that several emergency room and internal medicine staff managed both patients. We interviewed 28 hospital staffs on the procedures used to prepare and administer intravenous medication and manipulate intravenous devices. From the interviews, we found that 3 nurses and 1 emergency rescuer handled both patients. However, the evidence was not very clear and most of the staffs interviewed did not remember the Korean patient. No emergency room staff had symptoms of malaria in the succeeding weeks. Further investigation of blood samples from the 36 staffs and 34 patients who were in the emergency room were negative for malaria, as determined by PCR amplification of
P. falciparum 18s rRNA gene [
10] and indirect immunofluorescence assay.
To confirm this possible nosocomial transmission, sequence analysis of parasites was performed. Genomic DNA as prepared from a 3-ml blood sample from Case 1 using a DNA extraction kit (Macherey-Nargal, Düren, Germany). DNA from 2 thin Giemsa films from Case 2 was isolated using DNAzol (Invitrogen, Carlsbad, California, USA). We amplified the
P. falciparum MSP-1 gene block 2 region with the allele-specific primer sets, K2F, M2F, and R2F as the forward, and C3R as the reverse (AF061126 226-579). We amplified the block 17 region with K16F and M16F as the forward and C3flaR as the reverse (AB276005 4662-5057) by PCR, as described previously [
11]. PCR amplifications for the 2 patients were performed separately at different laboratories to avoid contamination. To compare the sequence of the 2 patients'
P. falciparum samples and to demonstrate that there was no contamination, each of the PCR amplifications was performed with DNA from a frozen
P. falciparum blood sample from Myanmar as the positive control.
RESULTS
A 360-bp PCR product was obtained for MSP-1 block 2 region from both patients using primer sets K2F and C3R. A 279-bp PCR product was obtained from the Myanmar control DNA. A 390-bp PCR product was obtained for block 17 from both patients using the primer sets M16F and C3flaR (
Fig. 1). The PCR product from the Myanmar control sample was obtained with the other primer set, K16F and C3flaR (data not shown). All PCR products were cloned and directly sequenced for confirmation. The sequences were aligned using CLUSTAL_X [
12] with manual corrections. The sequence alignment of the block 2 region revealed that the 2 sequences from the 2 patients were exactly the same (
Fig. 2). The second analysis, based on block 17, also showed exactly the same sequence. To confirm the origin of falciparum malaria, we confirmed the full sequence of MSP-1 gene by using DNA isolated from the Korean patient (case 1).
DISCUSSION
Nosocomial malaria usually involves a single incident of transmission to individual patients or hospital staffs by accidental needle-stick injuries, blood transfusions, or organ transplants [
13-
15]. We clearly demonstrated the nosocomial transmission of malaria between our 2 patients based on molecular investigations.
In the epidemiologic investigation, several nosocomial routes of transmission could be excluded. We confirmed the clearness of the donor's blood of malaria and the absence of mosquitoes inside and outside the hospital. We concluded that a natural transmission of malaria by a mosquito was not possible, because, aside from the inhospitable environmental conditions of the hospital for
Anopheles, the time period was too short. Unfortunately, no foci of exposure to contaminated intravenous solutions, catheters, syringes, or other devices were identified, because our investigation took place 20 days after the second patient was regarded as nosocomial transmission and because the incident which led to transmission occurred in a busy and congested emergency room. The remaining thin Giemsa-stained blood smears from the Greek patient were the only evidence of nosocomial infection. Blood films have been used in similar studies to confirm nosocomial infection by molecular investigation [
4].
To compare the sequences of parasites from the 2 patients, we selected the MSP-1 gene which contains highly variable repeat arrays [
16]. It provides an example of how interhelical exchange of blocks of dimorphic sequences may generate new alleles during sexual recombination [
17]. We compared the highly polymorphic tripeptide repeats domain (block 2) and non-repetitive domains (block 17), the most variable regions in MSP-1 gene (
Fig. 3). The sequence analysis of block 2 from both patients revealed same sequence containing a haplotype of '3111131111-111121' as described by Ferreira et al. [
16]. The sequence of the Myanmar control contained #16 haplotype '3111221', which was isolated from Vietnam. These results indicate that there was no contamination in the PCR amplification. The sequences of the Block 17 region from both patients also had 100 % identities with the haplotype of 'Q-ANG-L'. These results strongly suggest nosocomial infection between these 2 patients. There was a similar study on nosocomial infection via glucose meter which was confirmed by genotyping [
5].
A report of death from falciparum malaria in a patient is a cause for alarm for public health officials. The present case of nosocomial transmission is a good example of how several factors, sometimes difficult to foresee, can influence the effectiveness of infection control measures in a hospital. There is great need to review healthcare practices rigorously to manage infectious diseases and to enhance public knowledge. Our study delivers a strong message to improve hospital safety and infection control, and to develop countermeasures in safety management in the medical environment. In addition, there is great need to increase awareness of falciparum malaria due to global warming in an effort to prevent its establishment.
ACKNOWLEDGEMENTS
This work was supported by the intramural grant of the Korea CDCP (4837-302-210-13). The authors wish to thank Dr. Dorina G. Bustos of RITM, Philippines, for reading the manuscript and for her valuable criticism. Her co-work was made possible by a WHO/WPRO-funded 'Scientific Writing Workshop' at the RITM, Philippines.
References
- 1. Centers for Disease Control and Prevention, Republic of Korea. Available from: http://stat.cdc.go.kr/
- 2. Abulrahi HA, Bohlega EA, Fontaine RE, al-Seghayer SM, al-Ruwais AA. Plasmodium falciparum malaria transmitted in hospital through heparin locks. Lancet 1997;349:23-25.
- 3. Alweis RL, DiRosario K, Conidi G, Kain KC, Olans R, Tully JL. Serial nosocomial transmission of Plasmodium falciparum malaria from patient to nurse to patient. Infect Control Hops Epidemiol 2004;25:55-59.
- 4. Jain SK, Persaud D, Perl TM, Pass MA, Murphy KM, Pisciotta JM, Scholl PF, Casella JF, Sullivan DJ. Nosocomial malaria and saline flush. Emerg Infect Dis 2005;11:1097-1099.
- 5. Moro ML, Romi R, Severini C, Casadio GP, Sarta G, Tampieri G, Scardovi A, Pozzetti C. Maria Outbreak Group. Patient-to-patient transmission of nosocomial malaria in Italy. Infect Control Hops Epidemiol 2002;23:338-341.
- 6. Centers for Disease Control and Prevention, Republic of Korea. Communicable Diseases Monthly Report. 2007, 6:CDMR; (No. 52).
- 7. Lee WJ, Klein TA, Kim HC, Choi YM, Yoon SH, Chang KS, Chong ST, Lee IY, Jones JW, Jacobs JS, Sattabongkot J, Park JS. Anopheles kleini, Anopheles pullus, and Anopheles sinensis: potential vectors of Plasmodium vivax in the Republic of Korea. J Med Entomol 2007;44:1086-1090.
- 8. Shin EH, Kim TS, Lee HW, Lee JS, Lee WJ. Vector competence of Anopheles lesteri Baisas and Hu (Diptera: Culicidae) to Plasmodium vivax in Korea. Korean J Parasitol 2002;40:41-44.
- 9. Shin EH, Lee WJ, Lee HI, Lee DK, Klein TA. Seasonal population density and daily survival of anopheline mosquitoes (Diptera: Culicidae) in a malaria endemic area, Republic of Korea. J Vector Ecol 25;30:33-40.
- 10. Snounou G, Viriyakosol S, Zhu XP, Jarra W, Pinheiro L, do Rosario VE, Thaithong S, Brown KN. High sensitivity of detection of human malaria parasites by the use of nested polymerase chain reaction. Mol Biochem Parasitol 1993;61:315-320.
- 11. Kaneko O, Kimura M, Kawamoto F, Ferreira MU, Tanabe K. Plasmodium falciparum: allelic variation in the merozoite surface protein 1gene in wild isolates from southern Vietnam. Exp Parasitol 1997;86:45-57.
- 12. Thompson JD, Gibson , Plewniak F, Jeanmougin F, Higgins DG. The CLUSTAL_X windows interface: flexible strategies for multiple sequence. Nucleic Acids Res 1997;24:4876-4882.
- 13. Babinet J, Gay F, Bustos D, Dubarry M, Jaulmes D, Nquyen L. Transmission of Plasmodium falciparum by heart transplantation. Transplant Proc 1991;303:1515-1516.
- 14. Crafa F, Gugenheim J, Fabiani P, Di Marzo L, Militerno G, Iovine L, Goubaux B, Mouiel J. Possible transmission of malaria by liver transplantation. Transplant Proc 1991;23:2664.
- 15. Lattau LA. Nosocomial transmission and infection control aspects of parasites and ectoparasitic diseases. Part II. Blood and tissue parasites. Infect Control Hops Epidemiol 1991;12:111-121.
- 16. Ferreira MU, Ribeiro WL, Tonon AP, Kawamoto F, Stephen MR. Sequence diversity and evolution of the malaria vaccine candidate merozoite surface protein-1 (MSP-1) of Plasmodium falciparum. Gene 2003;304:65-75.
- 17. Kerr PJ, Ranford-Cartwright LC, Walliker D. Proof of intragenic recombination in Plasmodium falciparum. Mol Biochem Parasitol 1994;66:241-248.
- 18. Tanabe K, Sakihama N, Walliker D, Babiker H, Abdel-Muhsin AA, Bakote'e B, Ohmae H, Arisue N, Horii T, Rooth I, Färnert A, Björkman A, Ranford-Cartwright L. Allelic dimorphism-associated restriction of recombination in Plasmodium falciparum MSP1. Gene 2007;397:153-160.
Fig. 1Giemsa stained blood smears from the 2 patients. (A) Case 1 with 20% parasitemia. (B) Case 2 with 40% parasitemia. The slide for Case 2 was used for preparation of DNA.

Fig. 2PCR amplification of MSP-1 gene block 2 amplified with the primer sets K2F and C3R. The block 17 region was amplified with the primer sets M16Fand CflaR. (A) The Korean patient (Lane 1), and the Myanmar patient as a positive control (Lane 2), with vivax malaria (Lane 3) and distilled water (D.W.) (Lane 4) as negative controls. (B) The Greek patient (Lane 1), the Myanmar patient (Lane 2), and D.W (Lane 3). A-100 bp molecular marker was used for analysis (Lane M).

Fig. 3Alignment of the KI type tripeptide repeats in block 2 of the MSP-1 gene from the 2 patients, Case 1 (Lee1) and Case 2 (A1), and definition of the repeat haplotype.
*Loci are indicated by codon (amino acid) position in a sequence alignment or by block number [
18].